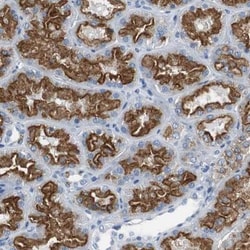
LRP2 Antibody, Novus Biologicals 0.1mL; Unlabeled:Anticorps, Polyclonal

missing translation for 'onlineSavingsMsg'
Learn More
Learn More
LRP2 Antibody, Novus Biologicals™
Rabbit Polyclonal Antibody has been used in 1 publication
Marque: Novus Biologicals NBP1-85292
Les retours ne sont pas autorisés pour ce produit.
Afficher la politique du retour.
Description
LRP2 Polyclonal specifically detects LRP2 in Human samples. It is validated for Immunohistochemistry, Immunohistochemistry-Paraffin.
Spécification
| LRP2 | |
| Polyclonal | |
| Immunohistochemistry, Immunohistochemistry-Paraffin 1:50 - 1:200 | |
| Q96SA4 | |
| LRP2 | |
| This antibody was developed against Recombinant Protein corresponding to amino acids:GFTSMSDRPGKRCAAEGSSPLLLLPDNVRIRKYNLSSERFSEYLQDEEYIQAVDYDWDPEDIGLSVVYYTVRGEGSRFGAIKRAYIPNFESGRNNLVQEVDLKLKYVMQPDGIAVDWVGRHIYWSDVKNKRIEVAKLDGRYRKWLISTDL | |
| 0.1 mL | |
| Lipid and Metabolism | |
| 4036 | |
| Human | |
| IgG |
| Immunohistochemistry, Immunohistochemistry (Paraffin) | |
| Unconjugated | |
| PBS (pH 7.2) and 40% Glycerol with 0.02% Sodium Azide | |
| calcium sensor protein, DBSlow-density lipoprotein receptor-related protein 2, EC 1.1.2.3, EC 3.4.21.9, Glycoprotein 330, GP330, Heymann nephritis antigen homolog, low density lipoprotein receptor-related protein 2, LRP-2, megalin | |
| Rabbit | |
| Affinity Purified | |
| RUO | |
| Primary | |
| Specificity of antibody verified on a Protein Array containing target protein plus 383 other non-specific proteins. | |
| Store at 4C short term. Aliquot and store at -20C long term. Avoid freeze-thaw cycles. |
Correction du contenu d'un produit
Veuillez fournir vos retours sur le contenu du produit en remplissant le formulaire ci-dessous.
Nom du produit
For Research Use Only
Vous avez repéré une opportunité d'amélioration ?Partager une correction de contenu